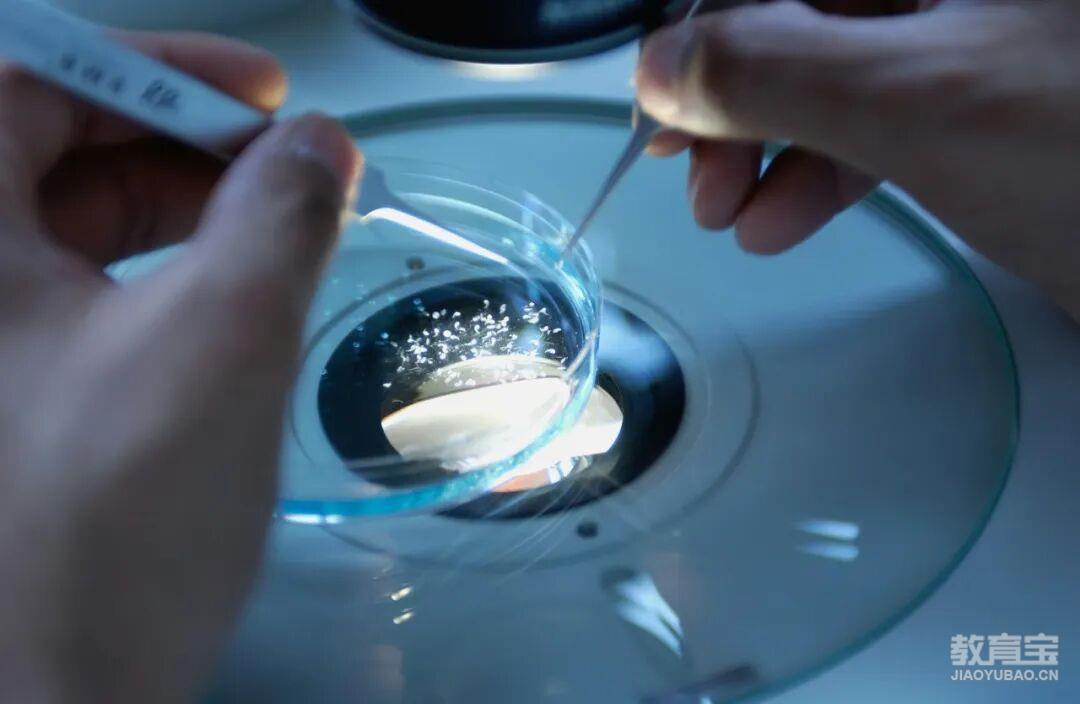

与梦偕行,超越自我
星度环球文化老师直接接听
 微信扫码拨号
微信扫码拨号

新加坡国立大学 × 复旦大学联合培养硕士:聚焦细胞治疗,抢占精准医疗风口!
2025年10月16日 更新
 新加坡国立大学复旦临港产业化创新平台精准健康与医疗理学硕士项目MScin PHM(细胞治疗方向)2026年QS全球排名第八/亚洲排名第*01新加坡国立大学简介National University of Singapore新加坡国立大学(National Univer...
新加坡国立大学复旦临港产业化创新平台精准健康与医疗理学硕士项目MScin PHM(细胞治疗方向)2026年QS全球排名第八/亚洲排名第*01新加坡国立大学简介National University of Singapore新加坡国立大学(National Univer...

新加坡国立大学复旦临港产业化创新平台精准健康与医疗理学硕士项目MScin PHM(细胞治疗方向)2026年QS全球排名第八/亚洲排名第*


01新加坡国立大学简介National University of Singapore新加坡国立大学(National University of Singapore,NUS)简称“新国大”,位于新加坡共和国,归教育部管辖,是新加坡的公立研究型大学,环太平洋大学联盟、亚洲大学联盟、全球大学校长论坛、Universitas 21等组织的成员学校。新国大在2025年泰晤士高等教育世界大学排名中位列第17名,2025年QS世界大学排名中位列第8名。截至2024年6月,新加坡国立大学共有16个学院,50多个专业,分布在新加坡肯特岗、武吉知马和欧南3大校区。并在全球设立3个海外分校、15个海外学院,另外还有3个教学中心。

02复旦临港产业化创新平台Fudan Lingang Industrialization Innovation Platform复旦临港产业化创新平台旨在将复旦工研院在研优质项目导入临港进行产业化,并以“平台+项目”的方式充分依托复旦大学已有的高水平研发平台和项目团队,不断吸引全球高端产业人才与创业项目聚集,打造政产学研全合作模式,推动创新成果孵化与技术产业化,从而构建核心关键领域创新基础和创业高地,营造交叉融合的研发氛围,进一步支撑临港智能制造与大健康等前沿产业发展。聚焦医疗未来产业方向,围绕医疗领域“共性技术研发”、“工程化系统”和“测试服务系统”等三个方面对前沿技术进一步研发、实现工程化加工制造提供服务全国、面向国际的高端测试和服务,促进技术传播转化、企业孵化吸引国内外优秀人才,重点培养医疗领域细胞免疫治疗方向人才,建设成为具有国际影响力的技术研发-工程-测试服务一体的创新中心。

03项目介绍project introduction精准健康与医疗理学硕士项目(细胞治疗方向)精准医疗作为医学界备受期待的新兴领域,将在未来几十年内彻底改变医疗保健行业。随着技术的进步(例如大数据、机器学习和人工智能)以及对基因的深入研究,精准医疗能够充分考虑个体在遗传基因、生活方式和环境因素等方面的差异,加深人们对人体生理学的了解,从而为不同人群提供精准的治疗和预防方案。新加坡国立大学精准健康与医疗硕士是一门跨学科的研究生课程,由学者、临床工作者、专业领域专家和行业人物共同主导。该课程旨在为医学和STEM(科学、技术、工程和数学)背景的学生提供相关知识和技能推动精准医疗赋能医疗保健行业的变革。新加坡国立大学医学院于2024年11月与复旦大学临港产业化创新平台签订了合作备忘录,将在今后10年(2025-2035)招收细胞治疗方向的精准健康和医疗硕士3000名,平均每年300人。细胞治疗方向的学生将获得额外的必修课程教育和“Capstone Project(顶点计划)”实习培养,使他们获得专业化、国际化的基因和细胞治疗(GCT)方面的良好知识和技术培训,服务于人类健康和疾病(衰老、肿瘤、生殖领域)治疗方案目标,并成为中国、东亚乃至全球的行业骨干、领袖人物。
04项目详情Project Details就业前景? 定向就业推荐精准健康和医疗硕士(细胞治疗方向)的毕业生将获得定向推荐,到国内985院校、三甲医院或港澳、新加坡、欧美地区院校企业从事细胞治疗、基因治疗、靶向治疗等精准医学、精准美容、精准健康方面的工作。? 推荐读博机会排名前2%-10%(视当期人才培养基金规模而定)的学生将获得推荐就读博士机会,并获得全额奖学金。? 终身资源扶持在新加坡国立大学精良硕士教育、“精准健康和医疗硕士”校友会和复旦大学合作平台的支撑下,所有毕业生都将得到终身的学术、商业、政策、资金及社会资源扶持,让他们成为国际基因和细胞治疗领域的专家、学者、教授或企业家、行业管理者。课程设置

实习培养? 顶点项目(Capstone Project)选择两年制的学生须完成一个顶点项目,顶点项目可分为学术或行业项目,学生将在导师的指导与监督下在9到12月内完成该项目,而后须提交一份项目报告和完成一次项目演示。细胞治疗方向的学生将额外获得一件细胞治疗产品的制作,一篇SCI论文的发表机会,为今后职业生涯奠定良好的开端。? 学术项目(细胞治疗方向)获得发表1-2篇SCI论文并得到第*作者(含共同第*作者)署名的机会,接触及累积学术研究经验可拓展学术界人脉表现优异者,可选择继续攻读博士学位(毕业*前2%的细胞治疗方向学生给予含全额奖学金的博士学位录取资格)。? 行业项目(细胞治疗方向)获得制作一件细胞治疗产品的机会,更早接触和累积行业工作经验,可拓展业界人脉,表现优异者,可获得就业机会。面向国内985院校和3000多家三级医院,全球知名医疗机构、制药企业,推介就职。与上海临港自贸区企业签订人才培育计划,获得优先落户机会。在上海、海南、澳门、香港、新加坡等地区创新创业或国际化细胞和基因治疗机构中任职。学制&学费? 学制1-2年? 学费:60,000新币(不含消费税)65,400新币(含9%消费税)申请要求? 学历:国内全日制统招本科以上? 语言:雅思(IELTS)内推6.0? 绩点:GPA=2.8/4或3.5/5? 专业:生物、医学、化学、计算机等? 奖学金申请条件:具备英文论文写作及科研能力中留服认证

以上就是项目的详细情况,如果关于项目还有其它疑问,或在申请过程中需要协助,欢迎联系我们,获取免费咨询和申请规划服务哦!以上内容请以学校发布的最新信息为准/ END /【声明】内容整理自网络,版权归原作者或平台所有,如有侵权请联系删除▉关于我们/ABOUT US

星度环球文化集团是一家环球A端资源方企业,致力于环球事业已12年有余。公司主要业务包括:翻译、教育、留学、科技及移民投资等。▉联系我们/CONTACT US

咨询或了解高校申请 / 留学申请 /翻译 / 语言课程 / 其它欢迎联系珠海公司沈老师 →

13926998689▉关注我们 /FOLLOW US

扫码关注星度环球文化

扫码关注星度国际翻译

搜索关注星度环球留学

搜索关注星度国际翻译

搜索关注星度环球留学星度国际翻译

搜索关注星度环球留学星度国际翻译


专业解答各类课程问题、介绍师资和学校情况
微信号:139******89
-
国考报名今日启动!留学生符合这些条件即可报考!
2026年国考今天正式开报!国家公务员局说,这次全国要招3.81万人,政策还是往多元人才靠——想进体制的留学生,可得抓住这个“上岸”机会。先把时间捋明白:网上报名10月15日8点到24日18点,资格审查同步到26日18点;11月1日0点到6日24点要确认缴费;准考证11...
2025/10/22 0:02:50 -
重磅!澳洲官宣取消留学生人数上限!
计划去澳洲留学的同学注意——刚传来个重磅!澳洲政府刚通过《2025年教育立法修正案(诚信及其它措施)》,直接废掉了留学生人数上限的立法限制!也就是说,澳洲非但没缩招国际学生,反而要升级教育体系——留学申请的“宽松期”可能要来了!这事不是突然的——2024年澳洲政府本来想...
2025/10/22 0:02:50 -
澳门理工大学26Fall硕博项目已开放申请,申请条件及专业汇总!
澳门理工大学(Macao Polytechnic University,MPU)是澳门公立多应用型高校,1981年创立,前身为东亚大学理工学院,2022年更现名。校训“普专兼擅,中西融通”,秉持“扎根澳门,背靠祖国,面向世界,争创”理念,治校标准是教学国际化、科研规范化...
2025/10/22 0:02:50 -
香港大学计算机与数据学院26fall申请开放!首轮12月1日截止
香港大学计算机与数据学院2026年秋季硕士申请通道已经开了,包含数据科学、计算机科学、电子商务及互联网计算这些前沿热门方向,现在都能同步申请。首轮截止时间是2025年12月1日,比去年早了小半个月。港校首轮申请向来竞争没那么激烈,奖学金机会也更多,打算申请的同学赶紧开始...
2025/10/22 0:02:50 -
注意!香港理工大学不再接受学校直接出具的*单!
2026年秋季入学(26FALL)开始,香港理工大学(PolyU)对内地及海外学生的申请材料提交方式改了——主要是*单、毕业证/学位证的官方验证,还有推荐信的提交规范,审核更看重权威和可追溯,就是要从根上保学术诚信。*受关注的是*单:所有申请者的*单都不能再用学校直接出...
2025/10/21 0:04:37
相关资讯
“星度环球文化”是横琴星度翻译有限公司深圳分公司在教育宝平台开设的店铺,若该店铺内信息涉嫌虚假或违法,请点击这里向教育宝反馈,我们将及时进行处理。











 在线咨询
在线咨询
 申请优惠
申请优惠
 预约试听
预约试听

 返回顶部
返回顶部